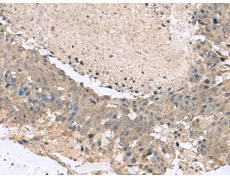
一抗

Background:
This gene encodes a member of the potassium channel tetramerization domain-containing protein family. Family members are identified on a structural basis and contain an amino-terminal domain similar to the T1 domain present in the voltage-gated potassium channel. Mutations in this gene have been associated with progressive myoclonic epilepsy-3. Alternative splicing results in multiple transcript variants.
Applications:
ELISA, WB, IHC
Name of antibody:
KCTD7
Immunogen:
Synthetic peptide of human KCTD7
Full name:
potassium channel tetramerization domain containing 7
Synonyms:
EPM3; CLN14
SwissProt:
Q96MP8
ELISA Recommended dilution:
5000-10000
IHC positive control:
Human brain and Human liver cancer
IHC Recommend dilution:
50-300
WB Predicted band size:
33 kDa
WB Positive control:
Hela cell lysate
WB Recommended dilution:
1000-5000
技術(shù)規(guī)格



 購物車
購物車 幫助
幫助
 021-54845833/15800441009
021-54845833/15800441009